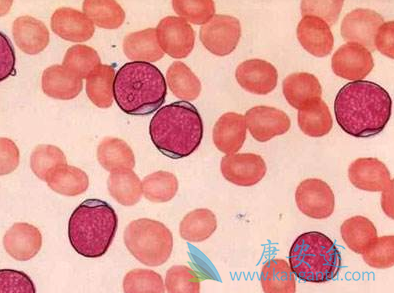
白血病病因 白血病病因

白血病也就是我们常说的血癌,是种常见的血液疾病,好发于年轻人,患了白血病不仅会对生命造成威胁,还会让不少家庭因此扛上巨额负债。目前尚未清除的确定引发白血病的病因是什么,但许多因素被认为与白血病发病有关。为了让大家更好的认识白血病,下边小编就为大家详细介绍一下白血病病因,希望能对大家有所帮助,做好白血病预防工作。
人类白血病的确切病因至今未明。许多因素被认为和白血病的发病有关。病毒可能是主要的因素。此外,尚有遗传因素、放射、化学毒物或药物等因素。某些染色体的异常与白血病的发生有直接关系,染色体的断裂和易位可使癌基因的位置发生移动和被激活,染色体内基因结构的改变可直接引起细胞发生突变,免疫功能的降低则有利于白血病的发病。
早已证实C型RNA肿瘤病毒或称逆转录病毒是哺乳类动物如小鼠、猫、牛、绵羊和灵长类动物自发性白血病的病因。这种病毒能通过内生的逆转录酶按照RNA顺序合成DNA的复制品,即前病毒,当其插入宿主的染色体DNA中后可诱发恶变。人类白血病的病毒病因研究已有数十年历史,但至今只有成人T细胞白血病肯定是由病毒引起的。
详情请访问 肿瘤 http://www.kangantu.org/














请简单描述您的疾病情况,我们会有专业的医学博士免费为您解答问题(24小时内进行电话回访)